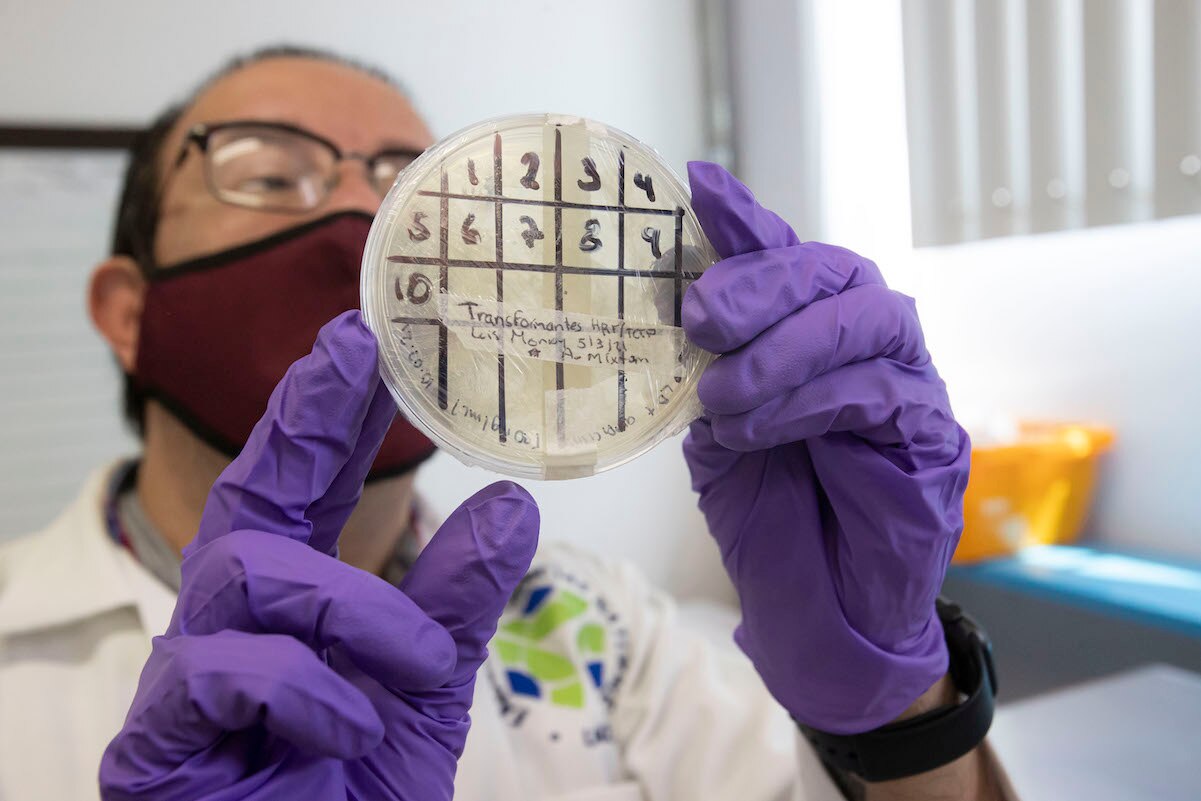
La vacuna contra el Covid-19 que desarrolla la UAQ podría aplicarse en niños

La autora, quien estudió periodismo en la UAQ, obtiene el Premio Bellas Artes de Cuento Hispanoamericano Nellie Campobello por el libro Quisiera quedarme quieta
30 / enero / 2026 | 14:34 hrs.

La autora, quien estudió periodismo en la UAQ, obtiene el Premio Bellas Artes de Cuento Hispanoamericano Nellie Campobello por el libro Quisiera quedarme quieta

La Universidad Autónoma de Querétaro y el empresario Edgardo Trejo firman convenio de colaboración para llevar a cabo un proyecto sustentable en la zona

Experto en patentes e investigador ve peligrosa la reciente convocatoria que lanza el Consejo

Clases presenciales dependerán de la viabilidad sanitaria, destaca la rectora; prevé un fin de año complejo ante posibilidad de nueva ola

El objetivo del taller es generar un vínculo entre el público con intereses recreativos o profesionales en la gastronomía y la Licenciatura en Gastronomía que imparte la máxima Casa de Estudios del estado

Un caso que ha pasado prácticamente desapercibido es el del científico mexicano Jean-Philippe Vielle Calzada, investigador del Laboratorio Nacional de Genómica para la Biodiversidad del Cinvestav en Irapuato, acusado por cuatro investigadoras por acoso y hostigamiento sexual

La universidad confirma que está incrementando el número de actividades presenciales en sus campus

Por la obra Serpiente del rayo, el joven José Manuel Hernández se lleva el segundo lugar en concurso del Instituto Nacional de Lenguas Indígenas

Universidad está en proceso de reformar su ley orgánica, que data de hace 35 años; perspectiva de género y sustentabilidad, temas a tratar
Esperaremos a los ensayos internacionales, explica la rectora. AMLO desconoce el trabajo que realizan las universidades, señala